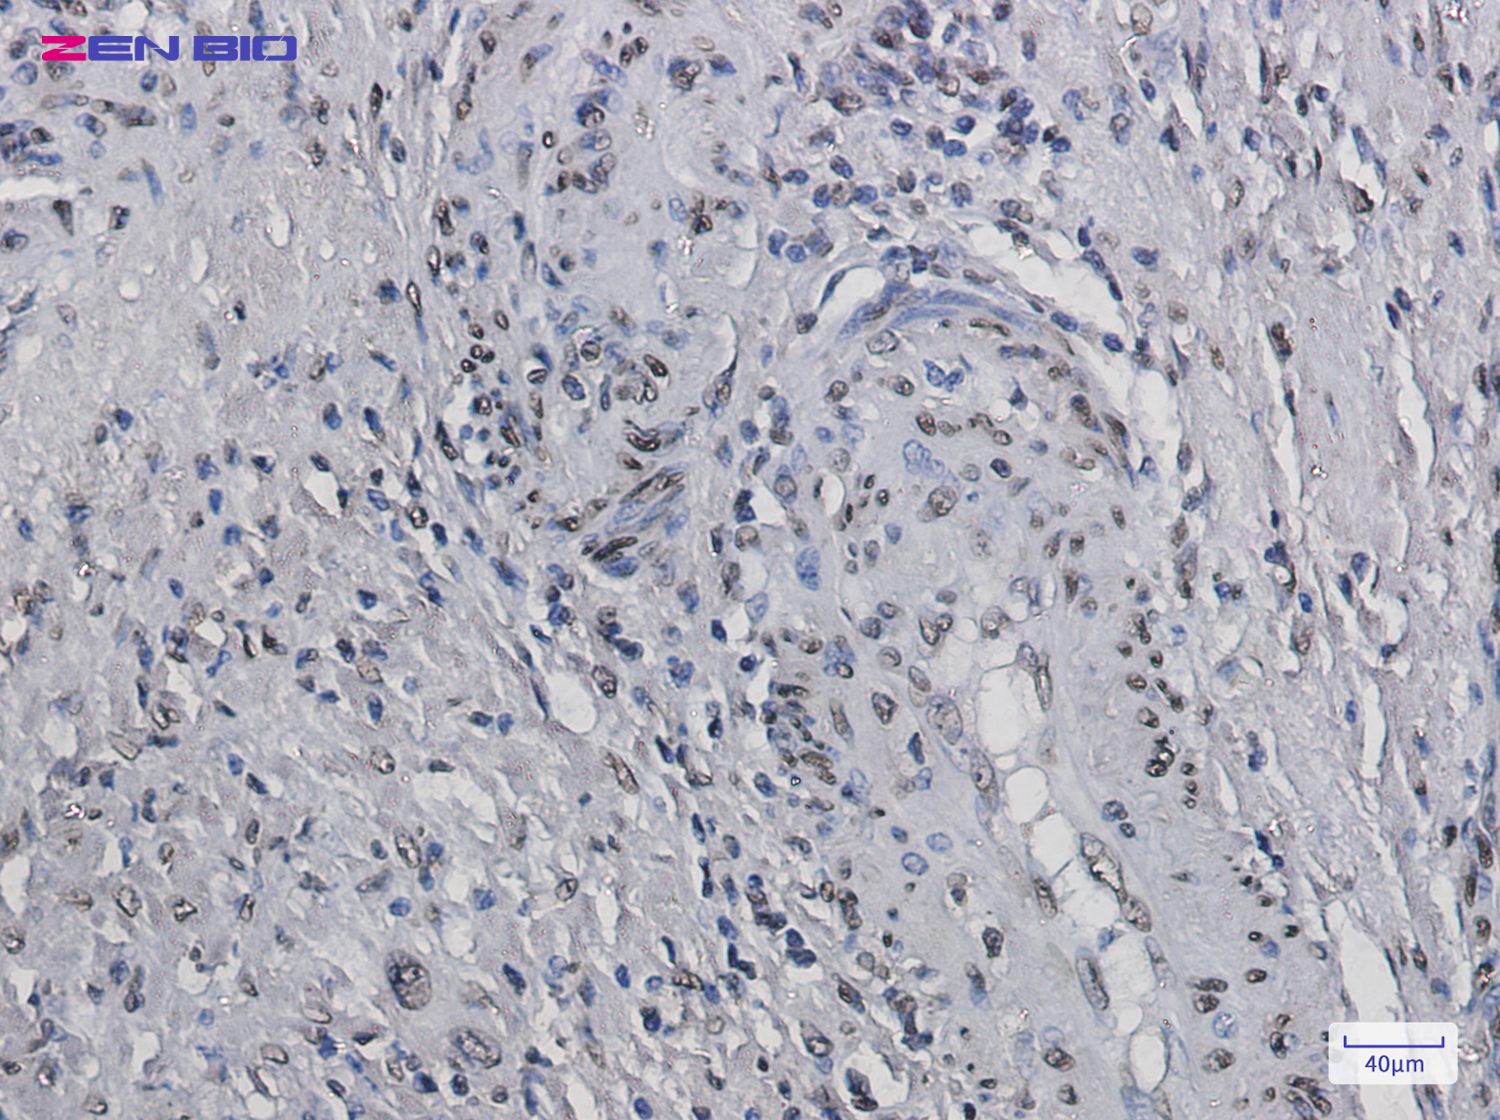
Immunohistochemistry of Histone H2B in paraffin-embedded Human colon cancer tissue using Histone H2B Rabbit pAb at dilution 1/20

-
Product Name
Anti-Histone H2B Rabbit antibody
- Documents
-
Description
Histone H2B Rabbit polyclonal antibody
-
Tested applications
WB, IHC-P, FC, IP
-
Species reactivity
Human, Mouse, Rat
-
Isotype
Rabbit IgG
-
Preparation
Antigen: A synthetic peptide of human Histone H2B
-
Clonality
Polyclonal
-
Formulation
Supplied in 50nM Tris-Glycine(pH 7.4), 0.15M Nacl, 40%Glycerol, 0.01% sodium azide and 0.05% BSA.
-
Storage instructions
Store at -20°C. Stable for 12 months from date of receipt.
-
Applications
WB: 1/5000
IHC: 1/20
FC: 1/20
IP: 1/20
-
Validations

Western blot detection of Histone H2B in K562,C6,3T3,Hela cell lysates using Histone H2B Rabbit pAb(1:1000 diluted).Predicted band size:14kDa.Observed band size:14kDa.
Immunohistochemistry of Histone H2B in paraffin-embedded Human colon cancer tissue using Histone H2B Rabbit pAb at dilution 1/20
-
Background
Swiss-Prot Acc.O60814.Core component of nucleosome. Nucleosomes wrap and compact DNA into chromatin, limiting DNA accessibility to the cellular machineries which require DNA as a template. Histones thereby play a central role in transcription regulation, DNA repair, DNA replication and chromosomal stability. DNA accessibility is regulated via a complex set of post-translational modifications of histones, also called histone code, and nucleosome remodeling.Has broad antibacterial activity. May contribute to the formation of the functional antimicrobial barrier of the colonic epithelium, and to the bactericidal activity of amniotic fluid.
Related Products / Services
Please note: All products are "FOR RESEARCH USE ONLY AND ARE NOT INTENDED FOR DIAGNOSTIC OR THERAPEUTIC USE"
